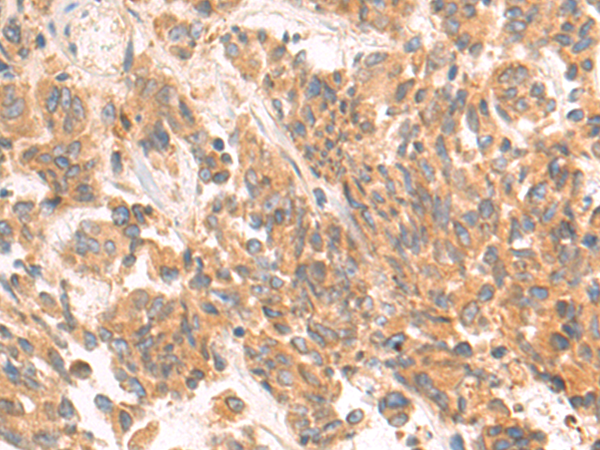

-
分类: 科研抗体货号: P08938别名: UCH-L3应用: WB,IHC反应种属: Human, Mouse, Rat
-
分类: 科研抗体货号: P08937别名:应用: IHC反应种属: Human
-
分类: 科研抗体货号: P08954别名: QCR2; UQCR2; MC3DN5应用: WB,IHC反应种属: Human, Mouse, Rat
-
分类: 科研抗体货号: P08936别名: GDX; G6PD; GET5; MDY2; UBL4; TMA24; DX254E; DXS254E应用: WB,IHC反应种属: Human, Mouse, Rat
-
分类: 科研抗体货号: P08972别名: PHM27应用: IHC反应种属: Human, Rat
-
分类: 科研抗体货号: P08953别名: QCR1; UQCR1; D3S3191应用: WB,IHC反应种属: Human, Mouse, Rat
-
分类: 科研抗体货号: P08935别名: CPUB1应用: WB,IHC反应种属: Human, Mouse, Rat
-
分类: 科研抗体货号: P08971别名: VIL; D2S1471应用: WB,IHC反应种属: Human
-
分类: 科研抗体货号: P08952别名: MAWD; PT-WD; UNRIP应用: WB,IHC反应种属: Human, Mouse, Rat
-
分类: 科研抗体货号: P08934别名: TCBA1; BMSC-UbP应用: WB,IHC反应种属: Human, Mouse

鄂公网安备42018502007531号
鄂公网安备42018502007531号

